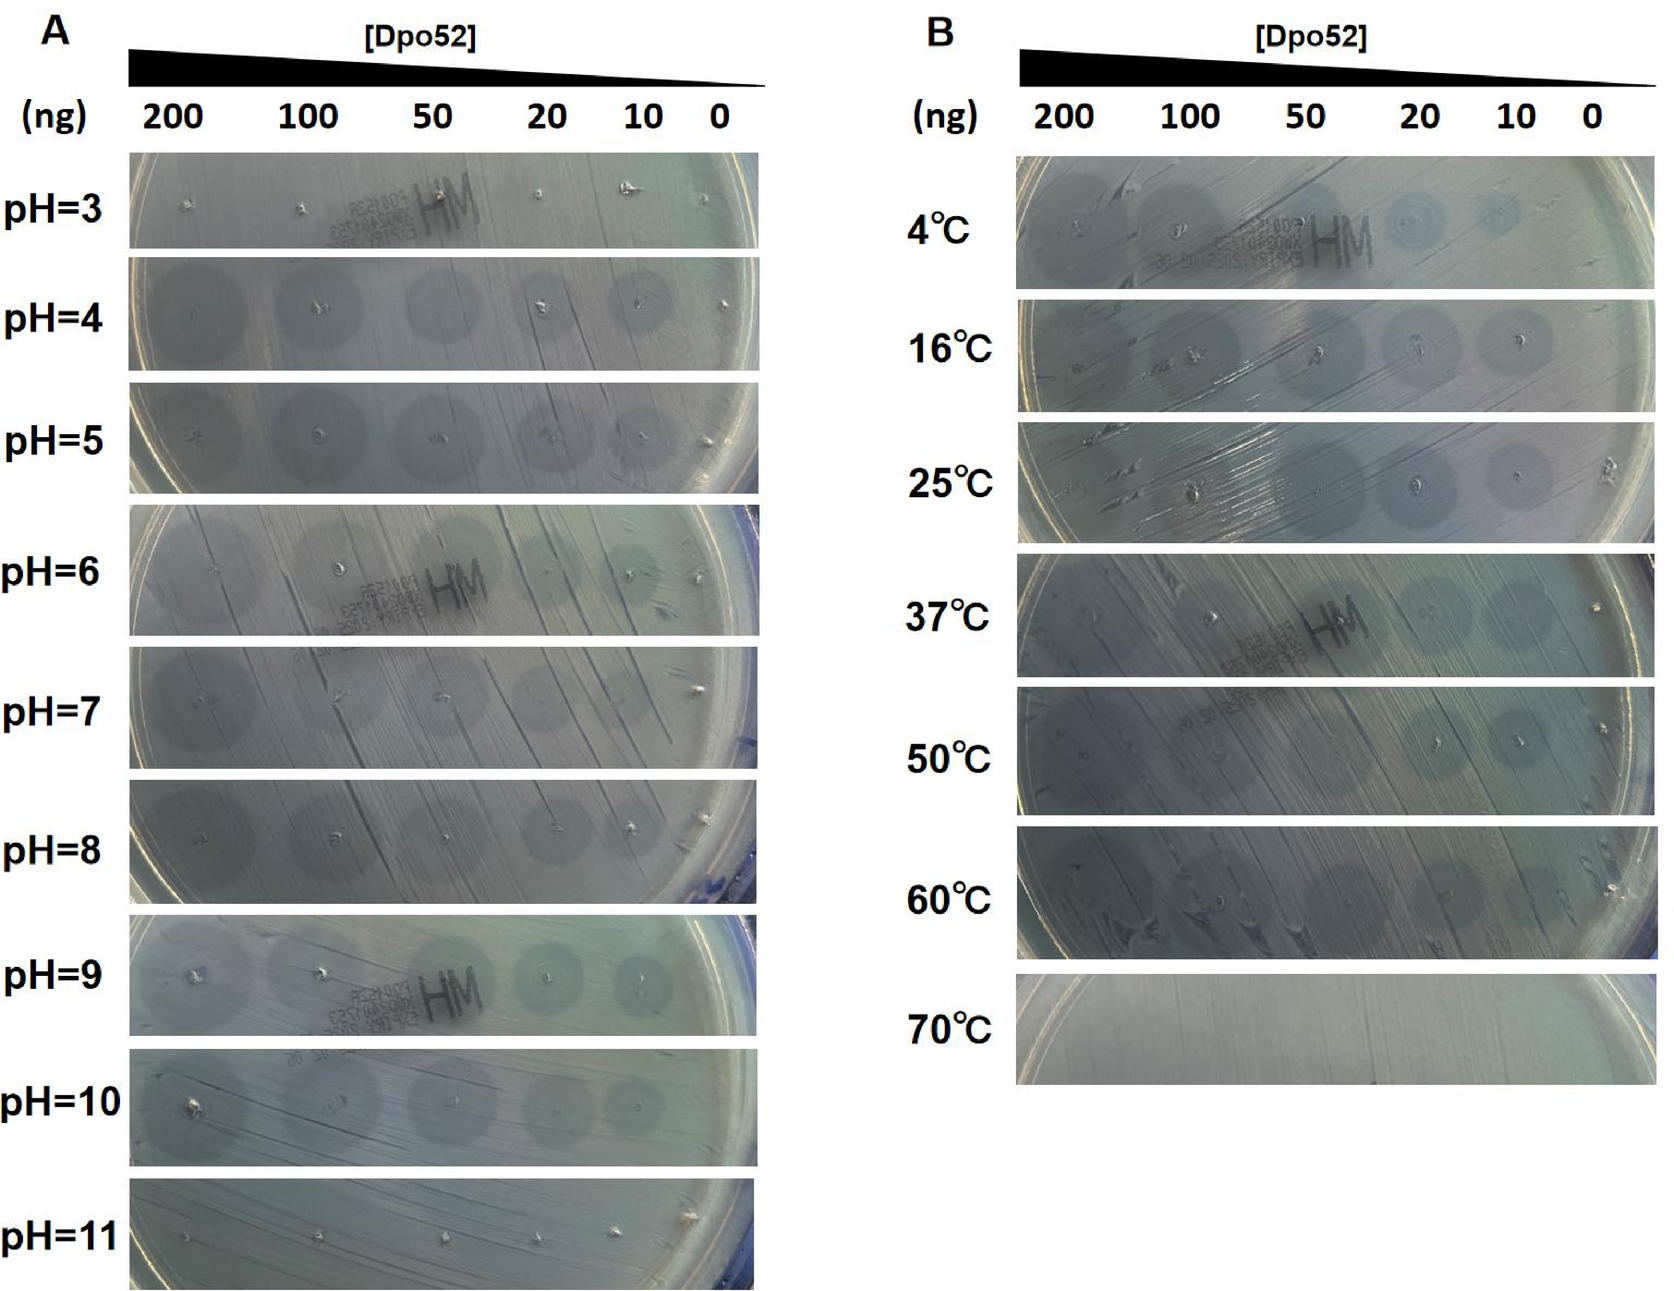
Fig. 5

Fig. 5
From: Identify and characterize a carbapenem-resistant Salmonella enteritidis phage depolymerase Dpo52
The stability of Dpo52. (A) Stability of Dpo52 at different pH values. Dpo52 at different pH values were spotted on lawns of S. enteritidis strain S3. (B) Stability of Dpo52 at different temperatures. Dpo52 at different temperatures were spotted on lawns of S. enteritidis strain S3.
